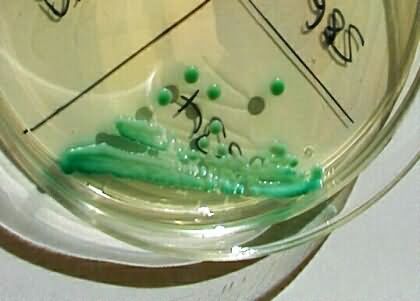

Candida albicans on a chromium-agar plate
|
Eukaryotic pathogens are often more easy to identify than to bacteria or viruses. They are, however, not easier to fight.
The yeast Candida albicans is mostly of low pathogenicity. Usually it provokes symptoms of disease only in persons with reduced resistance. Candida forms typical green colonies on chromium-agar plates.
|